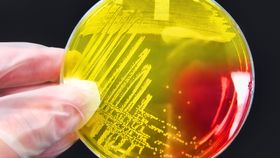

There’s no question about it: antibiotic resistance is a major problem without a current solution. Thanks to the overuse of antibiotics in both medical treatments and in agriculture, an increasing number of bacteria are developing a variety of ways to fend off these drugs, along with plenty of other standard treatments.
The rest of this article is behind a paywall. Please sign in or subscribe to access the full content.While scientists work on dealing with the problem by turning to underappreciated antibiotics or new solutions entirely, others are constantly unveiling the scale of the problem we face. The latest salvo comes courtesy of a University of Melbourne-led team, whose Nature Microbiology paper is anything but good news.
This bacterial species, Staphylococcus epidermis, is, as the name suggests, commonly present on the human skin. If that genus name sounds familiar, then you’re probably thinking about S. aureus and its antibiotic-resistant version.
Better known as methicillin-resistant S. aureus (MRSA), it tends to live harmlessly on one-in-30 people’s skin, but can prove deadly as an opportunistic infection for weakened patients in hospital wards. S. epidermis is much the same, in that it’s normally innocuous but can cause dangerous infections in treatment facilities.
Until now, though, MRSA was far more of a concern due to its aforementioned resistance.
However, a few years back, researchers at a Melbourne hospital began to see S. epidermis infections taking hold for far longer than expected. This triggered a multi-year research project designed to investigate its resistance to standard antibiotic treatments.
Taking samples from 78 hospitals scattered across 10 different countries, the team looked for genes that indicated it could defend itself or otherwise evade antibiotics. It turns out that there are three multidrug-resistant lineages of S. epidermis that have silently traversed the globe.
“Our study has uncovered the previously unrecognized international spread of a near pan-drug-resistant opportunistic pathogen,” the authors note in their paper.
Genetic mutations have rendered these strains protected against rifampicin, a widely used drug for a plethora of bacterial infections. Unexpectedly, said mutations have also given them a reduced susceptibility to teicoplanin and vancomycin, two very different types of antibiotic that are thought of as being a last line of defense against such infections.
The researchers don’t beat around the bush with their assessment of the strains’ rapid ascendances. They explain that the frequent deployment of rifampicin-treated equipment in hospitals – particularly invasive devices – has possibly driven the evolution of these microbes.
“Once trivialized as a contaminant,” it is, according to the authors, now leaning towards “potentially incurable infections.”
At present, it is unclear if or how such strains may be proliferating outside hospital environments. What is certain, however, is that something must be done immediately to stop its spread within hospitals, particularly in intensive care units.
“We know what we’re currently doing is just leading to more resistance,” senior author Prof. Ben Howden, a clinician and the director of the Microbiological Diagnostic Unit Public Health Laboratory at the Doherty Institute, said in a statement. “So, we urgently need to think about what we should be recommending instead.”
It’s obvious that, perhaps until now, S. epidermis was not a high priority for various health agencies.
On the US Centers for Disease Control and Prevention’s (CDC) website, they list the so-called superbugs that most concern them. MRSA is listed under the second-highest category of “serious threats,” while vancomycin-resistant S. aureus is listed in the lowest (but still noteworthy) category of “concerning threats.”
Notably absent is S. epidermis. It’s not on the World Health Organization’s (WHO) drug resistance site either. Its invasion by stealth, then, has come as a rather unpleasant surprise.